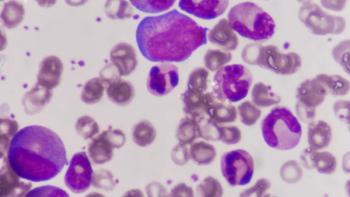
leukemia

Conference Coverage
about 1 month ago
Nutritional Support May Help Patients With Advanced Gastric Cancerabout 1 month ago
GLP-1 Associated With Colorectal Cancer Prevention, Research Findsabout 1 month ago
Walking Linked to Less Fatigue in Colorectal Cancer Survivorshipabout 1 month ago
Understanding Quality of Life Priorities in Later-Line Colon Cancerabout 2 months ago
Ziihera-Based Trial Results May Shift Care in HER2+ GI Cancer CareLatest Content

Self-Acupressure App Eases Fatigue in Ovarian Cancer

CAR-T Option Expands in Primary Central Nervous System Lymphoma

On Being a Symbol of Hope to Other Young Breast Cancer Survivors

FDA Fully Approves Braftovi Combo for BRAF V600E Metastatic Colorectal Cancer

Five-Year Cryoablation Data Show Durable Kidney Cancer Control

Shorts










Podcasts
Videos
All News

FDA granted fast track designation to AKY-1189 for adults with metastatic urothelial cancer after systemic therapy, aiming to speed development of the investigational drug.

The FDA granted fast track status to ART6043 plus Lynparza for patients with gBRCA-mutated HER2-negative breast cancer to accelerate drug development.

In an interview with CURE, Dr. Lakshmi Nayak explains how an FDA label update expands Yescarta access for relapsed or refractory primary CNS lymphoma.

Cancer-related fatigue may persist despite improved sleep or treated depression, underscoring it as a distinct and complex symptom.

Dr. William Audeh discusses how genomic subtyping can close the 38% mortality gap for Black women by identifying aggressive basal-type cancers.


Rodney Haring discusses Indigenous navigation, partnerships and prevention strategies to reduce cancer disparities and improve equity in Native communities

The FDA cleared an IND for FG001, allowing a U.S. trial in high-grade glioma, with first patient enrollment expected in second quarter of 2026.

Genentech announces FDA acceptance of giredestrant plus Afinitor for ER-positive, HER2-negative, ESR1-mutated advanced breast cancer treatment.

Thsi overview explains mesothelioma staging, diagnosis, side effects and treatment options from frontline through later lines to guide patient discussions.

Learn about Kaposi sarcoma causes, symptoms and the latest treatment options to help you navigate your diagnosis and talk with your oncologist.
Learn about stage 2 chronic myeloid leukemia, treatment options, side effects, and key questions to guide conversations with your oncologist.

Dr. Rodney Haring discusses strategies to reduce cancer mortality among Native Americans through patient navigation, clinical trials and tribal sovereignty.

Dr. Alex Francoeur of UC Irvine urges patients with ovarian cancer to ask questions, seek second opinions and build trusted relationships with oncologists.

A study led by Dr. J. William Harbour of UT Southwestern Medical Center marks a shift in how doctors predict the spread of uveal melanoma.



















